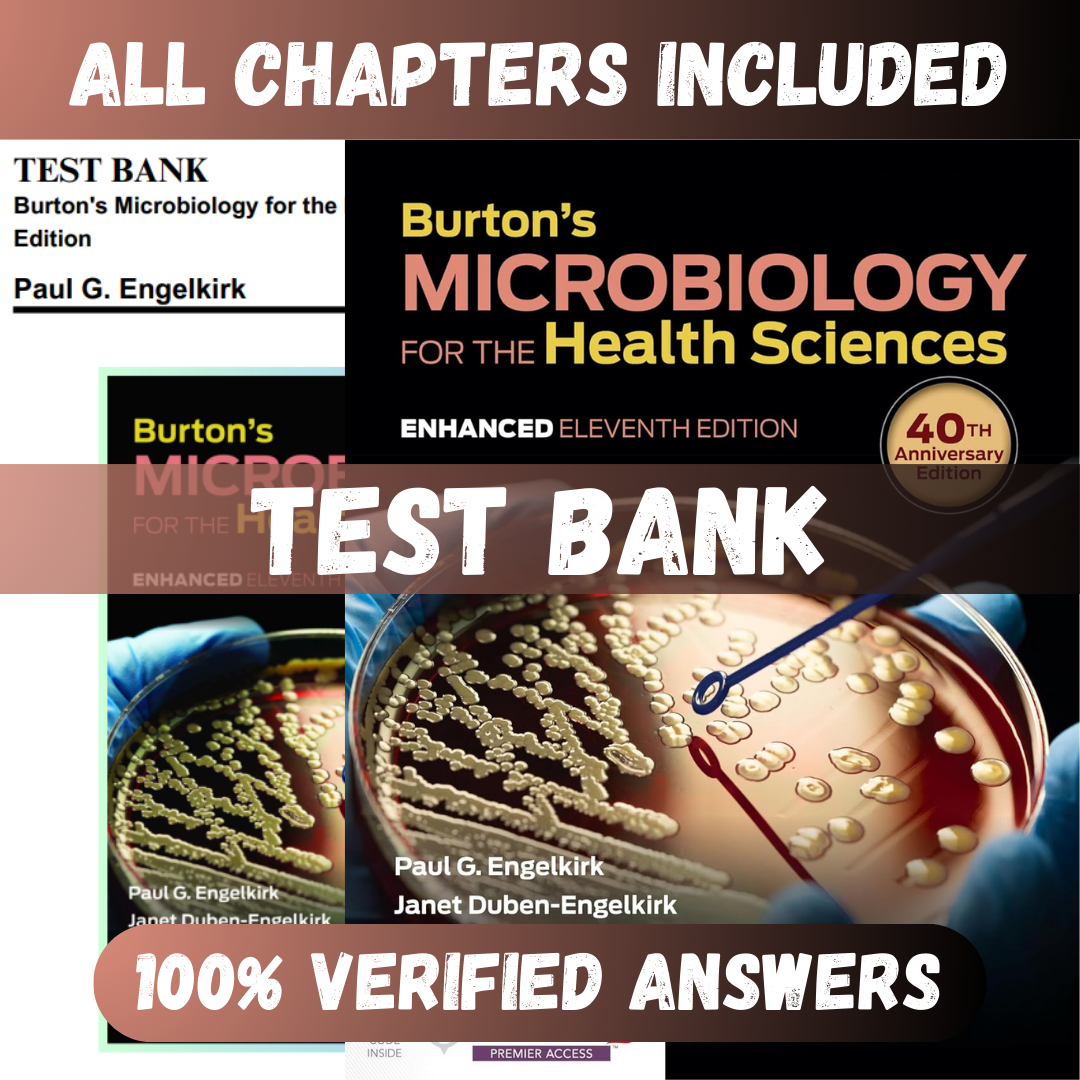
Test-Bank-Terrible-6-Burtons-Microbiology-for-the-Health-Sciences-Enhanced-Edition-11th-Edition-by-Paul-G-Engelkirk11-1

" Don't hesitate to buy... you will thank me later!!
This is the best decision that I have made to complement my NP program resources! I would highly recommend this to everyone, as it makes studying for exams very easy. I have passed all my exams with the help of this resource. And customer service was excellent!!